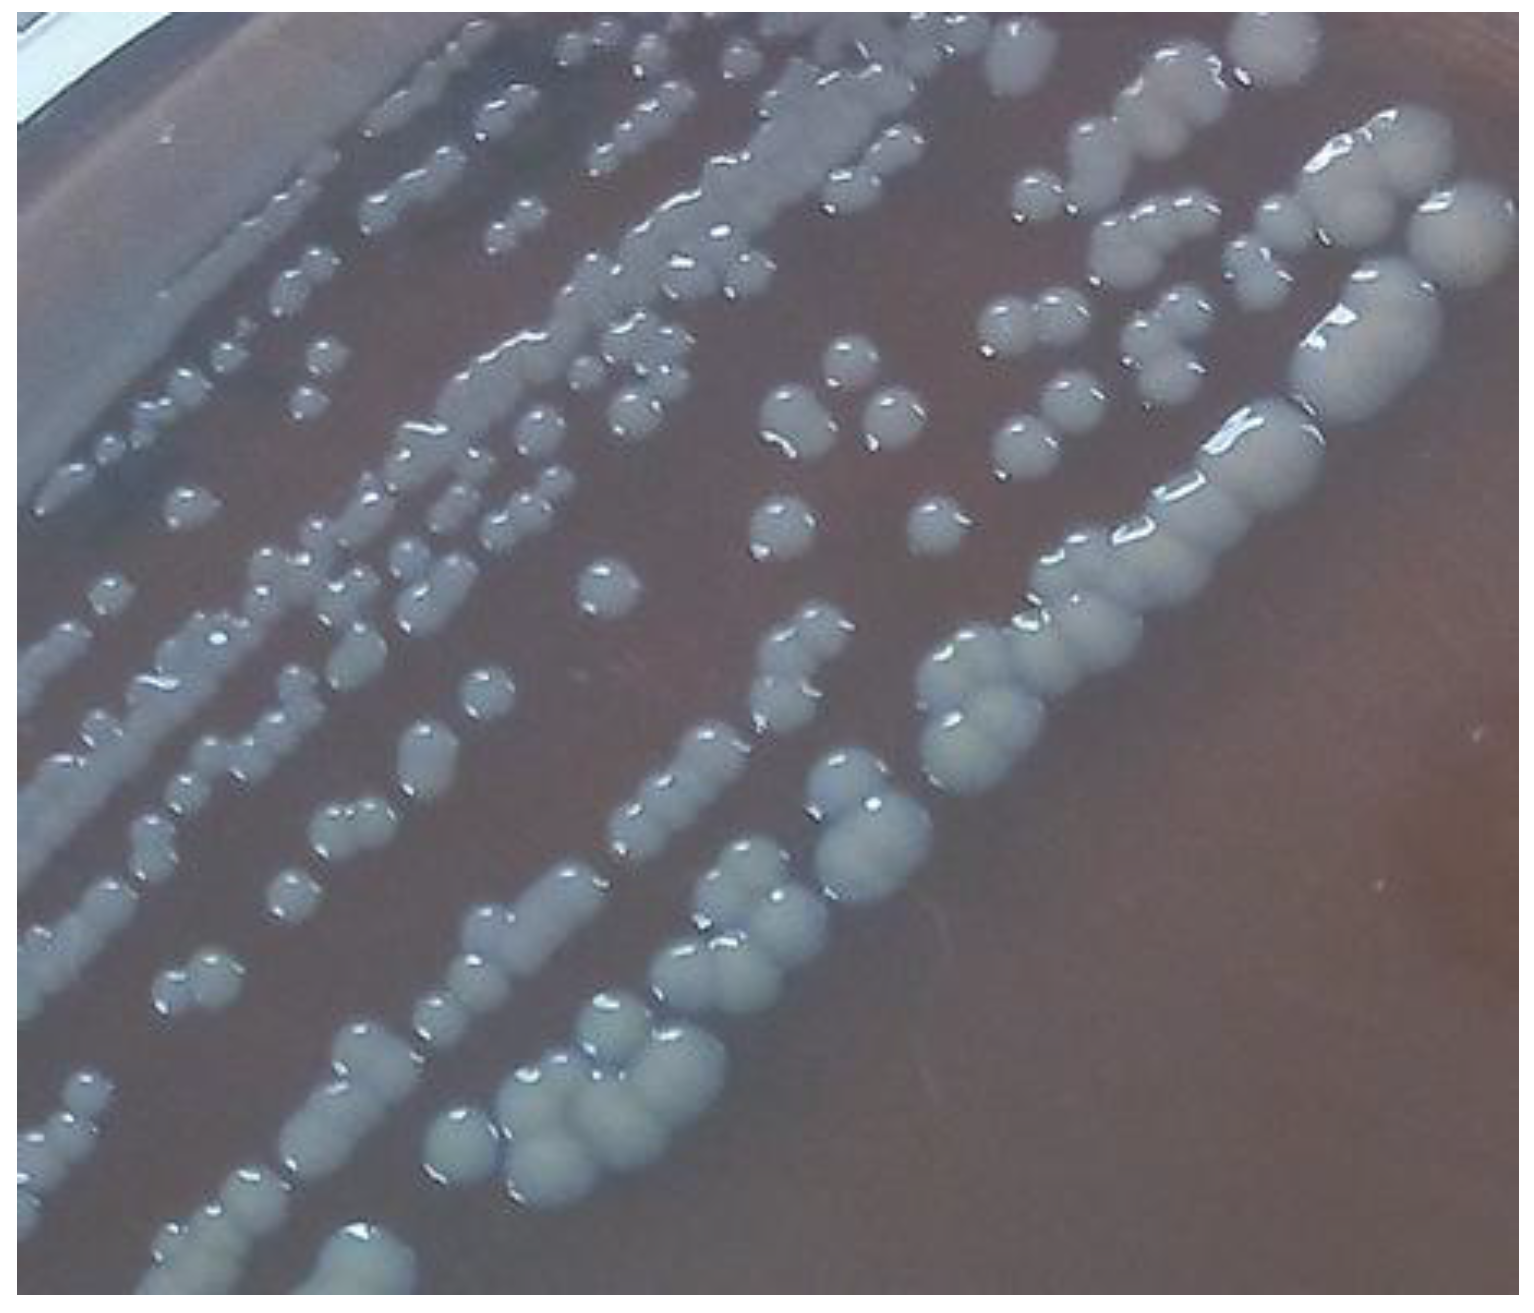
Foods 06 00106 g001

Effect of Food Residues in Biofilm Formation on Stainless Steel and Polystyrene Surfaces by Salmonella enterica Strains Isolated from Poultry Houses
Abstract
1. Introduction
2. Materials and Methods
2.1. Bacterial Strains and Growth Media
2.2. Tomato and Chicken Meat Juice Preparation
2.3. Polystirene Biofilm Formation Assays
2.4. Stainless Steel Biofilm Formation Assays
2.5. Determination of Morphotype
2.6. Motility Assays
2.7. Statistical Anaylisis
3. Results
4. Discussion
5. Conclusions
Author Contributions
Conflicts of Interest
References
- Grimont, P.A.; Weill, F. Antigenic Formulae of the Salmonella Serovars, 9th ed.; WHO Collaborating Centre for Reference and Research on Salmonella; WHO: Geneva, Switzerland, 2007. [Google Scholar]
- European Food Safety Authority. European Centre for Disease Prevention and Control the European Union summary report on trends and sources of zoonoses, zoonotic agents and food-borne outbreaks in 2015. EFSA J. 2016, 14, e04634. [Google Scholar]
- Markland, S.; Ingram, D.; Kniel, K.; Sharma, M. Water for Agriculture: The Convergence of Sustainability and Safety. Microbiol. Spectr. 2017, 5. [Google Scholar] [CrossRef] [PubMed]
- Wadamori, Y.; Gooneratne, R.; Hussain, M.A. Outbreaks and factors influencing microbiological contamination of fresh produce. J. Sci. Food Agric. 2017, 97, 1396–1403. [Google Scholar] [CrossRef] [PubMed]
- Steenackers, H.; Hermans, K.; Vanderleyden, J.; De Keersmaecker, S.C. Salmonella biofilms: An overview on occurrence, structure, regulation and eradication. Food Res. Int. 2012, 45, 502–531. [Google Scholar] [CrossRef]
- Hobley, L.; Harkins, C.; MacPhee, C.E.; Stanley-Wall, N.R. Giving structure to the biofilm matrix: An overview of individual strategies and emerging common themes. FEMS Microbiol. Rev. 2015, 39, 649–669. [Google Scholar] [CrossRef] [PubMed]
- Pontes, M.H.; Lee, E.J.; Choi, J.; Groisman, E.A. Salmonella promotes virulence by repressing cellulose production. Proc. Natl. Acad. Sci. USA 2015, 112, 5183–5188. [Google Scholar] [CrossRef] [PubMed]
- Solomon, E.B.; Niemira, B.A.; Sapers, G.M.; Annous, B.A. Biofilm formation, cellulose production, and curli biosynthesis by Salmonella originating from produce, animal, and clinical sources. J. Food Prot. 2005, 68, 906–912. [Google Scholar] [CrossRef] [PubMed]
- De Oliveira, D.C.V.; Fernandes, J.A.; Kaneno, R.; Silva, M.G.; Araújo, J.J.P.; Silva, N.C.C.; Rall, V.L.M. Ability of Salmonella spp. to produce biofilm is dependent on temperature and surface material. Foodborne Pathog. Dis. 2014, 11, 478–483. [Google Scholar] [CrossRef] [PubMed]
- Lamas, A.; Fernandez-No, I.C.; Miranda, J.M.; Vázquez, B.; Cepeda, A.; Franco, C.M. Biofilm formation and morphotypes of Salmonella enterica subsp. arizonae differs from those of other Salmonella enterica subspecies in isolates from poultry houses. J. Food Prot. 2016, 79, 1127–1134. [Google Scholar] [CrossRef] [PubMed]
- Lamas, A.; Miranda, J.M.; Vázquez, B.; Cepeda, A.; Franco, C.M. Biofilm formation, phenotypic production of cellulose and gene expression in Salmonella enterica decrease under anaerobic conditions. Int. J. Food Microbiol. 2016, 238, 63–67. [Google Scholar] [CrossRef] [PubMed]
- Wang, H.; Dong, Y.; Wang, G.; Xu, X.; Zhou, G. Effect of growth media on gene expression levels in Salmonella Typhimurium biofilm formed on stainless steel surface. Food Control 2016, 59, 546–552. [Google Scholar] [CrossRef]
- Wang, H.; Zhang, X.; Dong, Y.; Xu, X.; Zhou, G. Insights into the transcriptome profile of mature biofilm of Salmonella Typhimurium on stainless steels surface. Food Res. Int. 2015, 77, 378–384. [Google Scholar] [CrossRef]
- Li, J.; Feng, J.; Ma, L.; de la Fuente Núñez, C.; Gölz, G.; Lu, X. Effects of meat juice on biofilm formation of Campylobacter and Salmonella. Int. J. Food Microbiol. 2017, 253, 20–28. [Google Scholar] [CrossRef] [PubMed]
- Lamas, A.; Fernandez-No, I.C.; Miranda, J.M.; Vázquez, B.; Cepeda, A.; Franco, C.M. Prevalence, molecular characterization and antimicrobial resistance of Salmonella serovars isolated from northwestern Spanish broiler flocks (2011–2015). Poult. Sci. 2016, 95, 2097–2105. [Google Scholar] [CrossRef] [PubMed]
- Stepanović, S.; Ćirković, I.; Ranin, L. Biofilm formation by Salmonella spp. and Listeria monocytogenes on plastic surface. Lett. Appl. Microbiol. 2004, 38, 428–432. [Google Scholar] [CrossRef] [PubMed]
- Birk, T.; Ingmer, H.; Andersen, M.; Jørgensen, K.; Brøndsted, L. Chicken juice, a food-based model system suitable to study survival of Campylobacter jejuni. Lett. Appl. Microbiol. 2004, 38, 66–71. [Google Scholar] [CrossRef] [PubMed]
- Römling, U.; Bokranz, W.; Rabsch, W.; Zogaj, X.; Nimtz, M.; Tschäpe, H. Occurrence and regulation of the multicellular morphotype in Salmonella serovars important in human disease. Int. J. Med. Microbiol. 2003, 293, 273–285. [Google Scholar] [CrossRef] [PubMed]
- Karatzas, K.A.G.; Randall, L.P.; Webber, M.; Piddock, L.J.V.; Humphrey, T.J.; Woodward, M.J.; Coldham, N.G. Phenotypic and proteomic characterization of multiply antibiotic-resistant variants of Salmonella enterica serovar typhimurium selected following exposure to disinfectants. Appl. Environ. Microbiol. 2008, 74, 1508–1516. [Google Scholar] [CrossRef] [PubMed]
- White, A.P.; Gibson, D.L.; Grassl, G.A.; Kay, W.W.; Finlay, B.B.; Vallance, B.A.; Surette, M.G. Aggregation via the red, dry, and rough morphotype is not a virulence adaptation in Salmonella enterica serovar Typhimurium. Infect. Immun. 2008, 76, 1048–1058. [Google Scholar] [CrossRef] [PubMed]
- Seixas, R.; Machado, J.; Bernardo, F.; Vilela, C.; Oliveira, M. Biofilm Formation by Salmonella Enterica Serovar 1, 4,[5], 12: i:-Portuguese Isolates: A Phenotypic, Genotypic, and Socio-geographic Analysis. Curr. Microbiol. 2014, 68, 670–677. [Google Scholar] [CrossRef] [PubMed]
- Fabrega, A.; Vila, J. Salmonella enterica serovar Typhimurium skills to succeed in the host: Virulence and regulation. Clin. Microbiol. Rev. 2013, 26, 308–341. [Google Scholar] [CrossRef] [PubMed]
- Kroupitski, Y.; Golberg, D.; Belausov, E.; Pinto, R.; Swartzberg, D.; Granot, D.; Sela, S. Internalization of Salmonella enterica in leaves is induced by light and involves chemotaxis and penetration through open stomata. Appl. Environ. Microbiol. 2009, 75, 6076–6086. [Google Scholar] [CrossRef] [PubMed]
- Lianou, A.; Koutsoumanis, K.P. Strain variability of the biofilm-forming ability of Salmonella enterica under various environmental conditions. Int. J. Food Microbiol. 2012, 160, 171–178. [Google Scholar] [CrossRef] [PubMed]
- Genualdi, S.; Nyman, P.; Begley, T. Updated evaluation of the migration of styrene monomer and oligomers from polystyrene food contact materials to foods and food simulants. Food Addit. Contam. Part A 2014, 31, 723–733. [Google Scholar] [CrossRef] [PubMed]
- Castelijn, G.A.A.; van der Veen, S.; Zwietering, M.H.; Moezelaar, R.; Abee, T. Diversity in biofilm formation and production of curli fimbriae and cellulose of Salmonella Typhimurium strains of different origin in high and low nutrient medium. Biofouling 2012, 28, 51–63. [Google Scholar] [CrossRef] [PubMed]
- Koukkidis, G.; Haigh, R.; Allcock, N.; Jordan, S.; Freestone, P. Salad leaf juices enhance Salmonella growth, colonization of fresh produce, and virulence. Appl. Environ. Microbiol. 2017, 83, e02416-16. [Google Scholar] [PubMed]
- Addis, M.F.; Tanca, A.; Uzzau, S.; Oikonomou, G.; Bicalho, R.C.; Moroni, P. The bovine milk microbiota: Insights and perspectives from-omics studies. Mol. Biosyst. 2016, 12, 2359–2372. [Google Scholar] [CrossRef] [PubMed]
- Weiler, C.; Ifland, A.; Naumann, A.; Kleta, S.; Noll, M. Incorporation of Listeria monocytogenes strains in raw milk biofilms. Int. J. Food Microbiol. 2013, 161, 61–68. [Google Scholar] [CrossRef] [PubMed]
- Hamadi, F.; Asserne, F.; Elabed, S.; Bensouda, S.; Mabrouki, M.; Latrache, H. Adhesion of Staphylococcus aureus on stainless steel treated with three types of milk. Food Control 2014, 38, 104–108. [Google Scholar] [CrossRef]
- Jindal, S.; Anand, S.; Huang, K.; Goddard, J.; Metzger, L.; Amamcharla, J. Evaluation of modified stainless steel surfaces targeted to reduce biofilm formation by common milk sporeformers. J. Dairy Sci. 2016, 99, 9502–9513. [Google Scholar] [CrossRef] [PubMed]
- Giaouris, E.; Heir, E.; Desvaux, M.; Hébraud, M.; Møretrø, T.; Langsrud, S.; Doulgeraki, A.; Nychas, G.-J.; Kacániová, M.; Czaczyk, K.; et al. Intra- and inter-species interactions within biofilms of important foodborne bacterial pathogens. Front. Microbiol. 2015, 6, 841. [Google Scholar] [CrossRef] [PubMed]
- Almeida, F.A.; Pimentel-Filho, N.J.; Pinto, U.M.; Mantovani, H.C.; Oliveira, L.L.; Vanetti, M.C.D. Acyl homoserine lactone-based quorum sensing stimulates biofilm formation by Salmonella Enteritidis in anaerobic conditions. Arch. Microbiol. 2017, 199, 475–486. [Google Scholar] [CrossRef] [PubMed]
- Proctor, M.E.; Hamacher, M.; Tortorello, M.L.; Archer, J.R.; Davis, J.P. Multistate outbreak of Salmonella serovar Muenchen infections associated with alfalfa sprouts grown from seeds pretreated with calcium hypochlorite. J. Clin. Microbiol. 2001, 39, 3461–3465. [Google Scholar] [CrossRef] [PubMed]
- Vestrheim, D.; Lange, H.; Nygård, K.; Borgen, K.; Wester, A.; Kvarme, M.; Vold, L. Are ready-to-eat salads ready to eat? An outbreak of Salmonella Coeln linked to imported, mixed, pre-washed and bagged salad, Norway, November 2013. Epidemiol. Infect. 2016, 144, 1756–1760. [Google Scholar] [CrossRef] [PubMed]
- Sivapalasingam, S.; Barrett, E.; Kimura, A.; Van Duyne, S.; De Witt, W.; Ying, M.; Frisch, A.; Phan, Q.; Gould, E.; Shillam, P. A multistate outbreak of Salmonella enterica Serotype Newport infection linked to mango consumption: Impact of water-dip disinfestation technology. Clin. Infect. Dis. 2003, 37, 1585–1590. [Google Scholar] [CrossRef] [PubMed]
- Patel, J.; Singh, M.; Macarisin, D.; Sharma, M.; Shelton, D. Differences in biofilm formation of produce and poultry Salmonella enterica isolates and their persistence on spinach plants. Food Microbiol. 2013, 36, 388–394. [Google Scholar] [CrossRef] [PubMed]
- Yaron, S.; Römling, U. Biofilm formation by enteric pathogens and its role in plant colonization and persistence. Microb. Biotechnol. 2014, 7, 496–516. [Google Scholar] [CrossRef] [PubMed]
- Kuda, T.; Shibata, G.; Takahashi, H.; Kimura, B. Effect of quantity of food residues on resistance to desiccation of food-related pathogens adhered to a stainless steel surface. Food Microbiol. 2015, 46, 234–238. [Google Scholar] [CrossRef] [PubMed]
| Morphotype | ||
|---|---|---|
| Serotype/subspecies | 6 °C | 22 °C |
| S. Typhimurium Lhica T1 | SACW | RADR |
| S. Typhimurium Lhica T4 | SACW | RADR |
| S. Typhimurium Lhica T5 | SACW | RADR |
| S. Typhimurium Lhica T6 | SACW | RADR |
| S. Enteritidis Lhica ET1 | SACW | RADR |
| S. Bardo Lhica B2 | SACW | RADR |
| S. Newport Lhica N5 | SACW | RADR |
| S. Infantis Lhica I4 | SACW | RADR |
| S. Infantis Lhica I5 | SACW | RADR |
| S. enterica subsp. arizonae serovar 48:z4,z23,z32:-Lhica AZ2 | SACW | SAW |
| S. enterica subsp. arizonae serovar 48:z4,z23:-Lhica AZ6 | SACW | SAW |
| S. enterica subsp. salamae serovar 4,12:b:-Lhica SA3 | SACW | RADR |
| S. enterica subsp. salamae serovar 6,8:g,m,t:-Lhica SA2 | SACW | RADR |
| Strain | Motility (mm) at 22 °C | Motility (mm) at 6 °C |
|---|---|---|
| S. Typhimurium Lhica T1 | 15.50 ± 0.50 | 0.00 ± 0.00 * |
| S. Typhimurium Lhica T4 | 21.00 ± 1.00 | 6.00 ± 1.00 * |
| S. Typhimurium Lhica T5 | 25.10 ± 2.10 | 0.83 ± 0.29 * |
| S. Typhimurium Lhica T6 | 19.66 ± 1.53 | 2.17 ± 0.29 * |
| S. Enteritidis Lhica ET1 | 25.40 ± 3.20 | 2.00 ± 1.00 * |
| S. Bardo Lhica B2 | 19.83 ± 1.26 | 1.33 ± 0.58 * |
| S. Newport Lhica N5 | 19.50 ± 1.50 | 0.00 ± 0.00 * |
| S. Infantis Lhica I4 | 15.50 ± 0.50 | 6.00 ± 0.50 * |
| S. Infantis Lhica I5 | 12.00 ± 1.00 | 1.23 ± 0.25 * |
| S. enterica subsp. arizonae serovar 48:z4,z23,z32:-Lhica AZ2 | 20.07 ± 0.51 | 0.73 ± 0.40 * |
| S. enterica subsp. arizonae serovar 48:z4,z23:-Lhica AZ6 | 19.90 ± 0.79 | 1.00 ± 0.50 * |
| S. enterica subsp. salamae serovar 4,12:b:-Lhica SA3 | 15.33 ± 0.76 | 0.83 ± 0.57 * |
| S. enterica subsp. salamae serovar 6,8:g,m,t:-Lhica SA2 | 15.17 ± 1.04 | 1.83 ± 0.29 * |
| Average | 18.62 ± 3.97 | 1.77 ± 1.96 * |
| Strains | Media | |||||||
|---|---|---|---|---|---|---|---|---|
| 1/20 TSB | 1/20 Milk | TJ | CMJ | |||||
| St. | 6 °C | 22 °C | 6 °C | 22 °C | 6 °C | 22 °C | 6 °C | 22 °C |
| T1 | 0.112 ± 0.007 a | 0.366 ± 0.089 a,* | 0.092 ± 0.010 a,b | 0.262 ± 0.077 b,* | 0.079 ± 0.002 b | 0.061 ± 0.004 d | 0.083 ± 0.003 b | 0.100 ± 0.015 c |
| T4 | 0.149 ± 0.012 a | 0.395 ± 0.159 a,* | 0.084 ± 0.011 b | 0.139 ± 0.036 b,* | 0.083 ± 0.007 b | 0.059 ± 0.006 d,* | 0.080 ± 0.004 b | 0.088 ± 0.016 c |
| T5 | 0.146 ± 0.045 a | 0.169 ± 0.057 a | 0.099 ± 0.026 b | 0.160 ± 0.089 a | 0.078 ± 0.009 c | 0.080 ± 0.005 c | 0.077 ± 0.005 c | 0.111 ± 0.013 b,* |
| T6 | 0.152 ± 0.012 a | 0.219 ± 0.038 a,* | 0.090 ± 0.009 b | 0.144 ± 0.052 b,* | 0.057 ± 0.005 d | 0.071 ± 0.010 d | 0.076 ± 0.004 c | 0.113 ± 0.018 c,* |
| ET1 | 0.112 ± 0.007 a | 0.461 ± 0.069 a,* | 0.101 ± 0.014 a,b | 0.199 ± 0.032 b,* | 0.082 ± 0.008 b,c | 0.088 ± 0.010 c | 0.079 ± 0.010 c | 0.091 ± 0.015 c,* |
| B2 | 0.232 ± 0.037 a | 0.452 ± 0.042 a,* | 0.108 ± 0.026 b | 0.160 ± 0.033 b,* | 0.080 ± 0.010 c | 0.116 ± 0.012 c,* | 0.085 ± 0.003 c | 0.156 ± 0.022 b |
| N5 | 0.201 ± 0.022 a | 0.424 ± 0.049 a,* | 0.105 ± 0.017 b | 0.191 ± 0.035 b,* | 0.110 ± 0.013 b | 0.081 ± 0.002 c | 0.097 ± 0.025 b | 0.105 ± 0.034 c |
| I4 | 0.076 ± 0.008 a | 0.131 ± 0.025 a,* | 0.104 ± 0.039 a | 0.117 ± 0.061 a | 0.100 ± 0.021 a | 0.118 ± 0.032 a | 0.111 ± 0.039 a | 0.116 ± 0.025 a |
| I5 | 0.158 ± 0.012 a | 0.404 ± 0.135 a,* | 0.104 ± 0.021 b | 0.146 ± 0.021 b | 0.082 ± 0.003 c | 0.125 ± 0.022 b,* | 0.079 ± 0.004 c | 0.085 ± 0.022 c |
| AZ3 | 0.115 ± 0.013 a | 0.142 ± 0.063 a | 0.080 ± 0.010 b | 0.089 ± 0.020 b | 0.083 ± 0.005 b | 0.060 ± 0.009 c,* | 0.079 ± 0.006 b | 0.089 ± 0.019 b |
| AZ6 | 0.131 ± 0.015 a | 0.098 ± 0.011 a,* | 0.087 ± 0.020 b | 0.100 ± 0.018 a | 0.090 ± 0.010 b | 0.067 ± 0.010 b,* | 0.082 ± 0.007 c | 0.097 ± 0.012 a |
| SA2 | 0.642 ± 0.098 a | 0.563 ± 0.034 a | 0.130 ± 0.040 b | 0.300 ± 0.060 b,* | 0.079 ± 0.010 c | 0.081 ± 0.011 d | 0.080 ± 0.020 c | 0.121 ± 0.022 c,* |
| SA3 | 0.433 ± 0.019 a | 0.566 ± 0.061 a,* | 0.124 ± 0.032 b | 0.314 ± 0.039 b,* | 0.081 ± 0.001 c | 0.066 ± 0.009 d,* | 0.077 ± 0.012 c | 0.096 ± 0.009 c,* |
| 0.210 ± 0.161 a | 0.341 ± 0.165 a,* | 0.101 ± 0.020 b | 0.179 ± 0.070 b,* | 0.084 ± 0.015 b | 0.083 ± 0.023 c | 0.081 ± 0.014 b | 0.105 ± 0.022 c,* | |
| Strains | Media | |||||||
|---|---|---|---|---|---|---|---|---|
| 1/20 TSB | 1/20 Milk | TJ | CMJ | |||||
| St. | 6 °C | 22 °C | 6 °C | 22 °C | 6 °C | 22 °C | 6 °C | 22 °C |
| T1 | 0.161 ± 0.011 a | 0.212 ± 0.010 a,* | 0.098 ± 0.010 c | 0.118 ± 0.008 b | 0.090 ± 0.015 c | 0.080 ± 0.010 c | 0.123 ± 0.011 b | 0.127 ± 0.012 b |
| T4 | 0.182 ± 0.009 a | 0.228 ± 0.010 a,* | 0.080 ± 0.008 c | 0.107 ± 0.012 b | 0.083 ± 0.006 c | 0.111 ± 0.013 b | 0.131 ± 0.005 b | 0.112 ± 0.011 b |
| T5 | 0.134 ± 0.010 a | 0.172 ± 0.010 a,* | 0.076 ± 0.007 b | 0.106 ± 0.012 b,* | 0.073 ± 0.015 b | 0.079 ± 0.012 c | 0.071 ± 0.028 b | 0.101 ± 0.013 b,* |
| T6 | 0.124 ± 0.007 a | 0.124 ± 0.007 a,b | 0.089 ± 0.010 b | 0.111 ± 0.009 b,* | 0.060 ± 0.004 c | 0.056 ± 0.011 c | 0.120 ± 0.014 a | 0.136 ± 0.020 a |
| ET1 | 0.199 ± 0.010 a | 0.247 ± 0.008 a,* | 0.077 ± 0.010 b | 0.109 ± 0.008 b,* | 0.081 ± 0.009 b | 0.069 ± 0.009 c | 0.083 ± 0.019 b | 0.107 ± 0.009 b |
| B2 | 0.141 ± 0.012 a | 0.182 ± 0.008 a,* | 0.100 ± 0.013 b | 0.121 ± 0.009 b,* | 0.059 ± 0.010 c | 0.079 ± 0.010 c | 0.104 ± 0.009 b | 0.134 ± 0.011 b,* |
| N5 | 0.122 ± 0.011 a | 0.162 ± 0.009 a,* | 0.090 ± 0.009 b | 0.122 ± 0.008 b,* | 0.087 ± 0.010 b | 0.089 ± 0.012 c | 0.139 ± 0.021 a | 0.150 ± 0.009 a |
| I4 | 0.080 ± 0.012 a | 0.130 ± 0.011 a,* | 0.082 ± 0.010 a | 0.110 ± 0.008 a,* | 0.060 ± 0.008 b | 0.067 ± 0.005 b | 0.085 ± 0.010 a | 0.119 ± 0.010 a,* |
| I5 | 0.178 ± 0.002 a | 0.218 ± 0.012 a,* | 0.080 ± 0.010 c | 0.104 ± 0.008 c,* | 0.078 ± 0.012 c | 0.055 ± 0.015 d,* | 0.119 ± 0.012 b | 0.139 ± 0.009 b,* |
| AZ3 | 0.099 ± 0.011 a | 0.121 ± 0.009 a,* | 0.101 ± 0.021 a | 0.111 ± 0.010 a | 0.092 ± 0.022 a | 0.069 ± 0.012 b | 0.099 ± 0.010 a | 0.119 ± 0.005 a,* |
| AZ6 | 0.098 ± 0.006 a | 0.131 ± 0.010 a,* | 0.099 ± 0.018 a | 0.101 ± 0.008 b | 0.100 ± 0.020 a | 0.070 ± 0.005 c,* | 0.102 ± 0.030 a | 0.139 ± 0.026 a,* |
| SA2 | 0.155 ± 0.015 a | 0.198 ± 0.023 a,* | 0.103 ± 0.014 b | 0.110 ± 0.010 b,c | 0.110 ± 0.020 b | 0.098 ± 0.011 c | 0.108 ± 0.020 b | 0.135 ± 0.011 b,* |
| SA3 | 0.159 ± 0.012 a | 0.188 ± 0.010 a,* | 0.100 ± 0.006 b | 0.115 ± 0.009 b | 0.099 ± 0.010 b | 0.120 ± 0.010 b | 0.104 ± 0.016 b | 0.129 ± 0.013 b |
| 0.141 ± 0.036 a | 0.178 ± 0.042 a,* | 0.090 ± 0.010 b | 0.111 ± 0.012 b,c,* | 0.088 ± 0.016 b | 0.084 ± 0.020 c | 0.107 ± 0.035 b | 0.127 ± 0.014 b* | |
© 2017 by the authors. Licensee MDPI, Basel, Switzerland. This article is an open access article distributed under the terms and conditions of the Creative Commons Attribution (CC BY) license (http://creativecommons.org/licenses/by/4.0/).
Share and Cite
Paz-Méndez, A.M.; Lamas, A.; Vázquez, B.; Miranda, J.M.; Cepeda, A.; Franco, C.M. Effect of Food Residues in Biofilm Formation on Stainless Steel and Polystyrene Surfaces by Salmonella enterica Strains Isolated from Poultry Houses. Foods 2017, 6, 106. https://doi.org/10.3390/foods6120106
Paz-Méndez AM, Lamas A, Vázquez B, Miranda JM, Cepeda A, Franco CM. Effect of Food Residues in Biofilm Formation on Stainless Steel and Polystyrene Surfaces by Salmonella enterica Strains Isolated from Poultry Houses. Foods. 2017; 6(12):106. https://doi.org/10.3390/foods6120106
Chicago/Turabian StylePaz-Méndez, Alba María, Alexandre Lamas, Beatriz Vázquez, José Manuel Miranda, Alberto Cepeda, and Carlos Manuel Franco. 2017. "Effect of Food Residues in Biofilm Formation on Stainless Steel and Polystyrene Surfaces by Salmonella enterica Strains Isolated from Poultry Houses" Foods 6, no. 12: 106. https://doi.org/10.3390/foods6120106
APA StylePaz-Méndez, A. M., Lamas, A., Vázquez, B., Miranda, J. M., Cepeda, A., & Franco, C. M. (2017). Effect of Food Residues in Biofilm Formation on Stainless Steel and Polystyrene Surfaces by Salmonella enterica Strains Isolated from Poultry Houses. Foods, 6(12), 106. https://doi.org/10.3390/foods6120106

